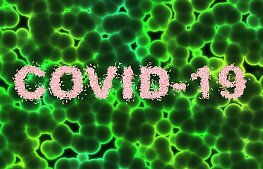

ТЕРМИНЫ И ОПРЕДЕЛЕНИЯ
В настоящей Политике конфиденциальности используются следующие термины и определения:
Сайт — является Сетевым изданием, зарегистрированным Федеральной службой по надзору в сфере связи, информационных технологий и массовых коммуникаций (Роскомнадзор). Представляет собой совокупность размещенных в сети Интернет web-страниц, объединенных единой темой, дизайном и единым адресным пространством домена APN-NN.COM, доступ к которому предоставляется Пользователям.
Администрация Сайта – уполномоченные сотрудники Сетевого издания, имеющие права управления Сайтом, действующие от имени редакции Сетевого издания, которые организуют и (или) осуществляет обработку персональных данных, а также определяет цели обработки персональных данных, состав персональных данных, подлежащих обработке, действия (операции), совершаемые с персональными данными.
Аккаунт — учетная запись Пользователя, создаваемая при регистрации на Сайте, позволяющая Редакции идентифицировать (авторизовать) каждого Пользователя посредством его логина и пароля.
Пользователь — лицо, имеющее доступ к Сайту посредством сети Интернет и использующее Сайт Сетевого издания, в том числе путем создания Аккаунта Пользователя на Сайте и размещающее или имеющее намерение размещать на Сайте комментарии и иную информацию.
Персональные данные — любая информация, относящаяся к прямо или косвенно определенному, или определяемому физическому лицу (субъекту персональных данных, Пользователю)
Информация, размещаемая Пользователем (Информация Пользователя) — текстовые материалы, фотоматериалы, видеоматериалы, гиперссылки на материалы, размещенные на других сайтах в сети Интернет, размещаемые Пользователями на Сайте в специальных формах (комментарии), а также в специально организованных Редакцией на Сайте сервисах.
Обработка персональных данных — любое действие (операция) или совокупность действий (операций), совершаемых с использованием средств автоматизации или без использования таких средств с персональными данными, включая сбор, запись, систематизацию, накопление, хранение, уточнение (обновление, изменение), извлечение, использование, передачу (распространение, предоставление, доступ), обезличивание, блокирование, удаление, уничтожение персональных данных.
Конфиденциальность персональных данных — обязательное для соблюдения получившим доступ к персональным данным лицом требование не допускать их распространения без согласия субъекта персональных данных или наличия иного законного основания.
Cookies — небольшой фрагмент данных, отправленный веб-сервером и хранимый на компьютере пользователя, который веб-клиент или веб-браузер каждый раз пересылает веб-серверу в HTTP-запросе при попытке открыть страницу соответствующего сайта.
IP-адрес — уникальный сетевой адрес узла в компьютерной сети, построенной по протоколу IP.
- ОБЩИЕ ПОЛОЖЕНИЯ
- Настоящая Политика конфиденциальности регламентирует предоставление, порядок обработки и использования персональных данных Пользователя. Оставляя данные на Сайте, Пользователь соглашается с Политикой конфиденциальности и защиты информации.
- Пользователь, регистрирующийся на Сайте, с целью получения доступа к сервисам Сайта, тем самым выражает свое полное согласие в соответствии со статьей 9 Федерального закона от 27 июля 2006 г. № 152-ФЗ «О персональных данных» на автоматизированную, а также без использования средств автоматизации, обработку и использование своих персональных данных.
- Принимая настоящую Политику конфиденциальности, Пользователь подтверждает, что:
— имеет необходимый объем гражданской дееспособности и права;
— волеизъявление Пользователя соответствует его внутренней воле и не ограничивается третьими лицами;
— Пользователь безоговорочно намеревается соблюдать и выполнять все условия изложенной ниже Политики конфиденциальности.
- В случае несогласия с условиями Политики конфиденциальности Пользователь должен прекратить использование Сайта Сетевого издания.
- Настоящая Политика конфиденциальности применяется только к сайту Сетевого издания «Агентство политических новостей – Нижний Новгород». Сетевое издание не контролирует и не несет ответственность за сайты третьих лиц, на которые Пользователь может перейти по ссылкам, доступным на сайте Интернет-издания.
- Администрация сайта не осуществляет проверку достоверности персональных данных, предоставляемых Пользователями Сайта Сетевого издания.
-
ПОЛИТИКА КОНФИДЕНЦИАЛЬНОСТИ
- Настоящая Политика конфиденциальности устанавливает обязательства Администрации Сайта по неразглашению и обеспечению режима защиты конфиденциальности персональных данных, которые Пользователь предоставляет по запросу Администрации сайта при регистрации на сайте.
- Персональные данные, разрешённые к обработке в рамках настоящей Политики конфиденциальности, предоставляются Пользователем путём заполнения регистрационной формы и включают в себя следующую информацию:
фамилию, имя, отчество Пользователя;
логин Пользователя
адрес электронной почты (e-mail).
Пользователь гарантирует достоверность предоставленных персональных данных и то, что персональные данные принадлежат Пользователю.
- Сетевое издание защищает Данные, которые автоматически передаются в процессе просмотра рекламных блоков и при посещении страниц, на которых установлен статистический скрипт системы:
- IP адрес;
- информация из cookies;
- информация о браузере (или иной программе, которая осуществляет доступ к показу рекламы);
- время доступа;
- адрес страницы, на которой расположен рекламный блок;
- реферер (адрес предыдущей страницы).
- Отключение cookies может повлечь невозможность доступа к частям Сайта, требующим авторизации.
- Сайт осуществляет сбор статистики об IP-адресах своих посетителей. Данная информация используется с целью выявления и решения технических проблем.
- Любая иная персональная информация, не указанная выше (используемые браузеры и операционные системы и т.д.) подлежит хранению и нераспространению, за исключением случаев, предусмотренных в п.п. 5.2. и 5.3. настоящей Политики конфиденциальности
- ЦЕЛИ СБОРА ПЕРСОНАЛЬНОЙ ИНФОРМАЦИИ ПОЛЬЗОВАТЕЛЯ
Персональные данные Пользователя Администрация Сайта может использовать в целях:
- Идентификации Пользователя, зарегистрированного на Сайте, а также для оформления заявки на размещение рекламы и (или) заключения сопутствующего Договора.
- Предоставления Пользователю доступа к персонализированным ресурсам Сайта.
- Установления с Пользователем обратной связи, включая направление уведомлений, запросов, касающихся использования Сайта, оказания услуг, обработка запросов и заявок от Пользователя.
- Предоставления Пользователю эффективной технической поддержки при возникновении проблем, связанных с использованием Сайта.
- Предоставления Пользователю с его согласия, обновлений специальных предложений, новостной рассылки и иных сведений от имени Сетевого издания или от имени его официальных Партнеров.
- Осуществления рекламной деятельности с согласия Пользователя.
- Предоставления доступа Пользователю на Сайты или сервисы партнеров Сетевого издания с целью получения информации и обновлений.
- СПОСОБЫ И СРОКИ ОБРАБОТКИ ПЕРСОНАЛЬНОЙ ИНФОРМАЦИИ
- Обработка персональных данных Пользователя осуществляется без ограничения срока, любым законным способом, в том числе в информационных системах персональных данных с использованием средств автоматизации или без использования таких средств.
- Пользователь соглашается с тем, что Администрация Сайта вправе передавать персональные данные третьим лицам, в частности, операторам электросвязи, исключительно в целях улучшения взаимодействия между пользователем и Сетевым изданием, предоставляя важную и актуальную информацию Пользователю.
- Персональные данные Пользователя могут быть переданы уполномоченным органам государственной власти только по основаниям и в порядке, установленным законодательством РФ.
- При утрате или разглашении персональных данных вследствие получения злоумышленниками несанкционированного доступа к Сайту, Администрация Сайта информирует Пользователя об утрате или разглашении персональных данных.
- Администрация Сайта принимает необходимые организационные и технические меры для защиты персональной информации Пользователя от неправомерного или случайного доступа, уничтожения, изменения, блокирования, копирования, распространения, а также от иных неправомерных действий третьих лиц.
- Администрация сайта совместно с Пользователем принимает все необходимые меры по предотвращению отрицательных последствий, вызванных утратой или разглашением персональных данных Пользователя.
-
ОБЯЗАТЕЛЬСТВА, НАЛАГАЕМЫЕ ПОЛИТИКОЙ КОНФИДЕНЦИАЛЬНОСТИ
-
Пользователь обязуется:
- Предоставить при регистрации и последующем пользовании — информацию о персональных данных, необходимую для пользования Сайтом.
- Обновлять предоставленные персональные данные в случае их изменения.
-
Администрация Сайта обязуется:
- Использовать полученную информацию исключительно для целей, указанных в п. 4 настоящей Политики конфиденциальности.
- Обеспечить хранение конфиденциальной информации в тайне, не разглашать без предварительного письменного разрешения Пользователя, а также не осуществлять продажу, обмен, опубликование, либо разглашение иными возможными способами переданных персональных данных Пользователя, за исключением п.п. 5.2. и 5.3. настоящей Политики Конфиденциальности.
- Принимать меры предосторожности для защиты конфиденциальности персональных данных Пользователя согласно порядку, обычно используемого для защиты такого рода информации в существующем деловом обороте.
-
ДОПОЛНИТЕЛЬНЫЕ УСЛОВИЯ
- Администрация Сайта вправе вносить изменения в настоящую Политику конфиденциальности без согласия и дополнительного извещения Пользователя.
- Нововведения вступают в силу с момента их опубликования на Сайте. Пользователи могут отслеживать изменения в Политике конфиденциальности самостоятельно.
- Все предложения или вопросы по настоящей Политике конфиденциальности следует сообщать Администрации сайта.
- На сайте могут содержаться ссылки на другие сайты. Сайт Сетевого издания не несет ответственности за содержание, качество и политику безопасности этих сайтов. Данное заявление о конфиденциальности относится только к информации, размещенной непосредственно на Сайте